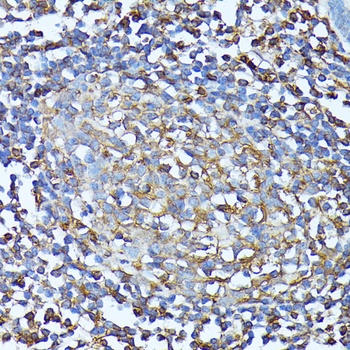
CXCR1 Antibody

You have no items in your shopping cart.
- CXCR1 antibody [orb10487]Featured

ICC, IF, IHC-P, WB
Rabbit
Polyclonal
Unconjugated
100 μg, 20 μg (trial size), 5 μg (trial size) - CXCR1 Rabbit Polyclonal Antibody [orb499586]Featured

WB
Human
Rabbit
Rabbit
Polyclonal
Unconjugated
100 μl, 50 μl, 200 μl - CXCR1 Antibody [orb626143]Featured

ELISA, IP, WB
Human, Mouse
Rabbit
Polyclonal
Unconjugated
100 μg, 50 μg - CXCR1 Rabbit Polyclonal Antibody [orb77571]
ELISA, IHC, WB
Human
Mouse, Rat
Rabbit
Polyclonal
Unconjugated
100 μg